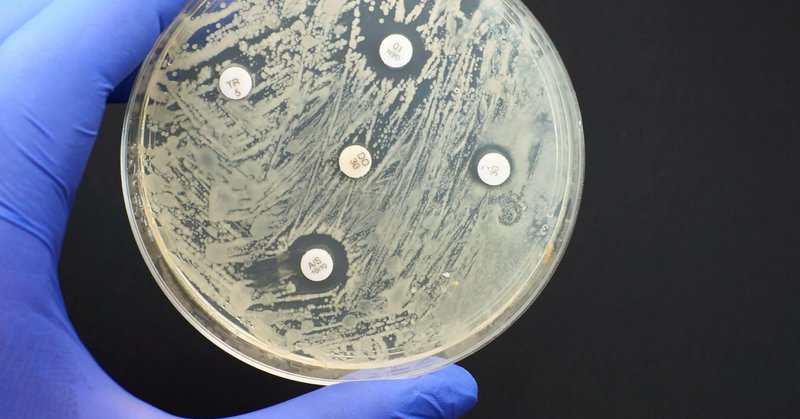
Tweet card summary image

AREST_AMR
@AREST_AMR
Followers
228
Following
639
Media
57
Statuses
308
The AREST project will generate national level data on the key sources, hot spots and drivers of antimicrobial resistance in the environment.
Galway, Ireland
Joined November 2018
📰🚨Call for papers for a special issue of the One Health journal: The presence of AROs & ARGs in the aquatic environment. For more information use the link: https://t.co/o8UirJIBcm
@DrJeanODwyer @Liam_P_Burke @DrMichaelRyanUL @BrigidHooban & Paul Hynds
0
6
8
Thank you to Andrew for his very thought provoking keynote address @EPAResearchNews @AREST_AMR @PublicHealth_A #AMR
Delighted to attend and commence the @AREST_AMR public engagement/project end meeting — Dearbhaile Morris and her large consortium should be very proud of their many high quality outputs that speak to #AMR, the environment and human health!
0
1
3
🔊 What has the AREST project taught us? 🗓️Why not come along to our event on June 15th where we will discuss key findings and recommendations from the AREST project and launch the final report! ⬇️Register here for FREE! https://t.co/oQHmqU0jo3
@arme_morris @EPAResearchNews
1
3
5
🔊Interested in antimicrobial resistance and the environment? 🗓️Why not come along to our event on June 15th where we will launch the final report for the AREST project! See below for more info & to register for FREE⬇️ https://t.co/oQHmqU0jo3
@EPAResearchNews @arme_morris
0
11
11
Well done to my @EUErasmusPlus trainee Aneta Kovarova who presented her work on #AMR in mute swans @ECCMID 23. Thanks also to @GrahamProle and the Midlands Ringing Group for their collaboration and @EPAResearchNews for part funding. #OneHealth @arme_morris @AREST_AMR
0
1
9
Tune into the "Fate of Wastewater" webinar next Tuesday evening to hear to hear more about the work completed as part of the AREST project. This event is hosted by the Chartered Institute of Water & Environmental Management. Details👇 https://t.co/OctOoRALcl
0
1
5
Our @DESIGN_UCC study on #STEC in Irish private wells is available now in @STOTEN_journal 🥳 Huge thanks & congrats to all co-authors! Thanks to all well owner volunteers & to @EPAResearchNews for funding! Our work continues with @GalwayDERIVE project https://t.co/VUB0MKxovY
1
12
24
Very excited to announce that our recent paper has been published in Nature Comms! - a 🧵 https://t.co/f6CzpcNYgS An ISO-certified genomics workflow for identification and surveillance of antimicrobial resistance @BenjaminHowden @torstenseemann @KristyHoran14 @TheDohertyInst
11
90
230
Check out this pre-print article titled 'First reported detection of the mobile colistin resistance genes, mcr-8 and mcr-9, in the Irish environment' written by @NiamhCahill10 as part of AREST. @arme_morris @GalwayOneHealth @EPAResearchNews @RyanInstitute
https://t.co/wzGE3DwVRf
biorxiv.org
The emergence and dissemination of mobile colistin resistance ( mcr ) genes across the globe poses a significant threat to public health, as colistin remains one of the last line treatment options...
0
2
8
Our @RyanInstitute @GalwayOneHealth annual conference starts on #OneHealth Day Nov 3rd, FREE via Zoom! Infectious Diseases & Zoonoses Antimicrobial Resistance Emerging Contaminants People, Nature & Environment Behavioural & Societal Change Register➡️ https://t.co/ZiT7hlOc0I
0
17
20
Why have 1 PhD supervisor when you can have 4? 😅 Myself & Drs Aaron Potito, Carlos Chique & Michelle McKeown are seeking a postgraduate student for this super cool @iCRAGcentre project tracking AMR in a lake over time- a truly multidisciplinary project! Deadline: 29th July!
0
17
41
#PhDposition alert! Me and @DrJeanODwyer are looking for an excellent microbiology &/or environmental science graduate for a 4 yr fully funded #OneHealth PhD in Galway @NUIGalwayMed studying #VTEC transport in the #water #environment on @DERIVE_Project Apply by June 24th!👇
1
43
54
New article from the AREST project now available online 👉 'A Longitudinal Survey of Antibiotic-Resistant Enterobacterales in the Irish Environment, 2019–2020'. 👉 https://t.co/icZU01dp00
@arme_morris @EPAResearchNews @onehealth_nuig @RyanInstitute @PierProject @maeveloufarrell
0
11
28
Looking for a #PostDoc developing rapid molecular assays? Just over a week left to apply for this exciting role @arme_morris lab in Galway on @EPAResearchNews DERIVE project - "DEtection and RIsk management of VTEC in the water Environment" RT's appreciated!
📢#PostDoc job alert! We are looking for someone with expertise in #qPCR and #LAMP to develop assays for environmental detection of #VTEC #STEC 2 yr post on the new @EPAResearchNews #DERIVE project @arme_morris lab in Galway! Please RT! https://t.co/9A8IVwTATS
0
8
8
Interesting paper from the AREST project examining the removal of antimicrobial resistant Enterobacteriaceae in Irish farm effluent using integrated constructed wetlands 👇 Check it out at the link below 👇 https://t.co/5uVuKKkA7L
0
5
14
“To save lives and economies, we must make progress [in the fight against #antibioticresistance] in the next decade by drawing on the lessons from the #COVID19 pandemic,” @UKAMREnvoy writes.
ft.com
To save lives and economies, we must make progress by drawing on lessons from Covid-19
0
12
28
33 areas currently discharge raw sewage daily as they have no treatment plant. EPA welcomes the news that Irish Water will soon commence building a new treatment plant and sewers at Kilmore Quay in Wexford. Work due to be complete in 2024 #EPAOEE #IrishWater
4
9
20
Check out the first ever joint ECDC-WHO/Europe report on Antimicrobial Resistance Surveillance in Europe 2022 – (2020 data) 💊🦠 https://t.co/XabNnSCmNu
0
7
11
📜Check out this gap analysis of research needs to understand the environmental dimension of antimicrobial resistance by @NiamhCahill10 💊🦠 https://t.co/F1j2YCykgp
@EPAResearchNews @RyanInstitute @arme_morris @onehealth_nuig @PierProject
0
1
5